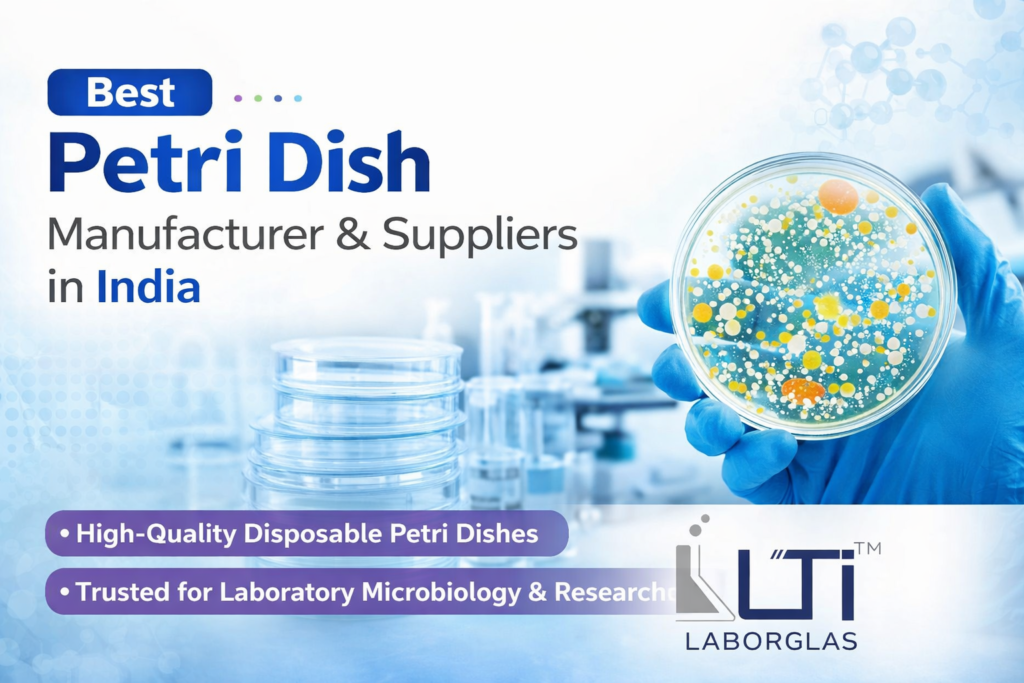
Best Petri Dish Manufacturer & Suppliers in India

Understanding the Role of Squibb Separating Funnels with PTFE Key Stopcocks in Precision Laboratory Extractions
In chemical, pharmaceutical, and analytical laboratories, liquid-liquid extraction is one of the most fundamental processes for purifying substances and isolating specific compounds. For extractions requiring high chemical resistance, precision separation, and adherence to international testing standards, choice of glassware becomes critical. Among premium laboratory setups globally, the Squibb Separating Funnel with a Short Stem and PTFE Plug (Model 6830, ASTM Standard) is highly preferred. Manufactured by Lab-Tech International (Lab-Tech Export) in Ambala Cantt, Haryana, this precise glassware engineered product complies completely with ASTM international quality metrics. What Makes the Squibb Design with PTFE Key Unique? Standard separating funnels come in pear or cylindrical shapes, but the Squibb design is structurally optimized with a wider top that tapers uniformly toward the base. This provides a distinct surface area advantage during shaking and fast phase separation. The PTFE Advantage Traditional glass stopcocks require constant lubrication (grease) to prevent seizing or freezing during high-vacuum or volatile chemical extractions. However, a PTFE (Polytetrafluoroethylene) Plug/Key Stopcock completely removes this bottleneck: Zero Grease Contamination: No lubricants are required, meaning your organic and aqueous phases remain 100% pure without grease residues leaching into the sample. Exceptional Chemical Inertness: PTFE is immune to almost all aggressive acids, solvents, and bases. Smooth, Leak-Proof Operation: Precise machining of the PTFE plug guarantees an airtight fit, minimizing vapor loss during volatile solvent extractions. Technical Specifications: Model 6830 (ASTM Standard) Lab-Tech International manufactures this item across multiple capacities to match micro-scale experiments as well as industrial research-scale extractions: Product Code Capacity (ml) Stopcock Bore (mm) Stopper Size Standard Packaging Qty 6830-60 60 ml 2 mm 16 1 Unit 6830-125 125 ml 2 mm 22 1 Unit 6830-250 250 ml 4 mm 22 1 Unit 6830-500 500 ml 4 mm 27 1 Unit 6830-1000 1000 ml 4 mm 27 1 Unit 6830-2000 2000 ml 6 mm 38 1 Unit Design Profile: Short Stem: Reduces the drainage travel path, minimizing liquid retention inside the stem and accelerating collection speeds. ASTM Standard Compliance: Ensures standardized joint sizing, uniform wall thickness, and accurate scale dimensions fitting into global lab networks without cross-brand compatibility issues. Core Applications of Squibb Separating Funnels The Squibb short-stem variant is integrated across multiple industrial workflows, including: 1. Liquid-Liquid Phase Extraction The primary utility is cleanly isolating a desired compound out of an aqueous mix into an immiscible organic solvent based on relative solubilities. 2. Analytical Sample Preparation Essential for initial cleaning phases before running sensitive chromatography (HPLC, GC-MS) or spectroscopy protocols, protecting columns from bulk impurities. 3. Purification and Solvent Recovery Used extensively during organic chemical synthesis to wash organic layers with brine or water, separating and recovering costly solvents while dropping reaction impurities. 4. Environmental Testing & Bio-Processing Utilized by environmental labs to isolate organic pollutants or pesticides out of heavy water samples, and by bio-labs to parse specific compounds from multi-layered biological extractions. Why Choose Lab-Tech Export as Your Manufacturing Partner? Founded under rigorous principles of quality and precision engineering by Mr. Yogesh Chauhan (CEO) in 2010, Lab-Tech International has fast tracked to become one of India’s most trusted manufacturers and exporters of Laboratory Glassware and Volumetric Instruments. Premium Borosilicate Glass: All items are manufactured using high-expansion borosilicate glass that resists thermal shocks and remains structurally sound under stressful laboratory temperature profiles. Custom Sizing Solutions: Capable of catering to bulk international orders with localized modifications as required. Globally Trusted Export Portfolio: Serving academic, health, and industrial research operations across various global markets directly out of the Science City of India (Ambala Cantt). Get an Instant Quote for Your Laboratory Requirements Are you preparing to scale up your laboratory inventory or look for a reliable OEM exporter for ASTM standard volumetric glassware? Connect directly with the expert technical team at Lab-Tech International to receive detailed spec sheets, competitive pricing matrices, and shipping terms: Official Product Link: Model 6830 – Squibb Separating Funnel with PTFE Plug Corporate Facility: 11-A, Herman City Road, Khudda Khurd, Ambala Cantt – Haryana (INDIA), Pin Code – 133006 Hotline: +91 98020-13010 Direct Email Contact: Info@Labtechexport.Com